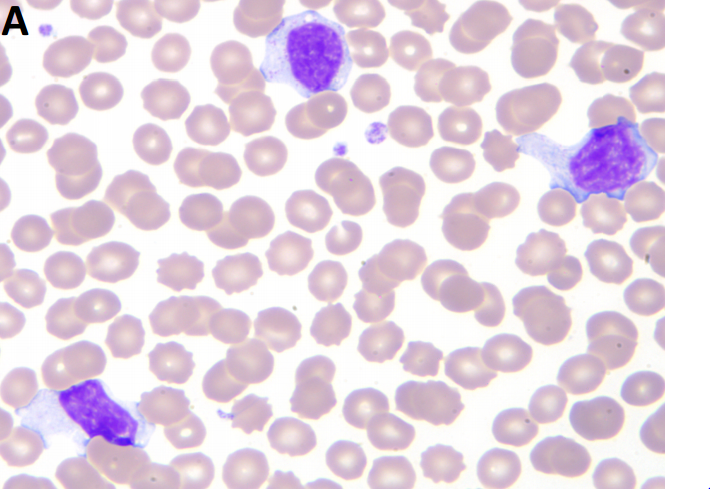
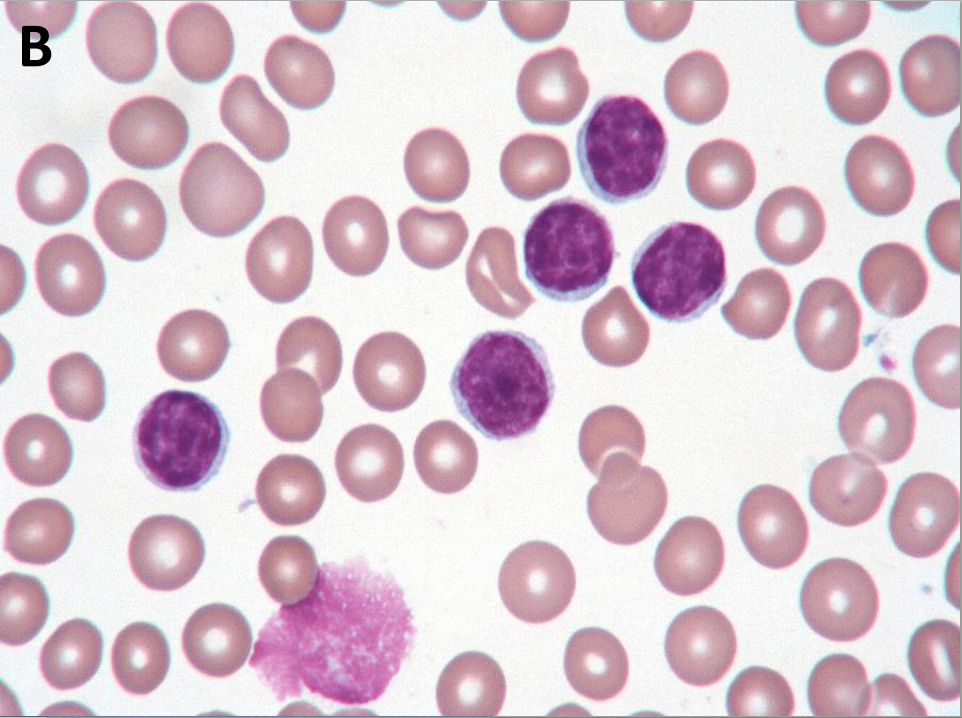
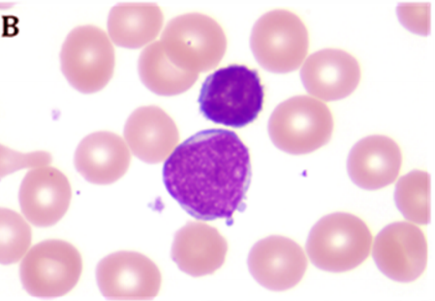

What does this patient have?
What demographic?
Normal/abberant immunophenotype?
Poly/monoclonal?
Symptoms?
Mononucleosis
Teenager
Normal
Polyclonal
Fatigue, pharyngitis, splenohepatomegaly
What does this patient have?
What demographics?
Normal/abberant immunophenotype?
Poly/monoclonal?
CLL
Elderly
Abnormal
Monoclonal
What is absolute lymphocytosis?
What is the difference between reactive or neoplastic? (Duration, Morphology, Absolute Count, Associated Clinical Findings, Flow cytometery)
>4,000/microL of lymphocytes
Reactive - Acute Duration, Heterogenous, 10-12K or less, Flow reveals polyclonal
Neoplastic - Chronic Duration, Homogenous (Monotonous), 20-40K, Flow reveals monoclonal
Clinical findings are actually pretty common, specific things such as excessive fatigue and weight loss push towards neoplastic
What other viruses/pathogens cause mono-like syndromes?
CMV, Adeno, Acute HIV, Toxo
How do we assess B cells for clonality?
Light chain restriction on cell surface (kappa v lambda) via flow or immunohistochem IgH variable gene PCR - One (mono) vs multiple (poly) rearrangements Immunophenotypic aberrancy (e.g. CD5 (T-cell marker) expression on B cells)
T/NK assessment for clonality?
TCR gene PCR
Immunophenotypic aberrancy
Flow assessment for clonality? What’s left vs right?

Left - Polyclonal
Right - Monoclonal
What is this cell indicative of disease?
What kind of cell is this?
What would be the next step to characterize these cells?
ALL Immature cell (Lymphoblast) Flow cytometery (determine clonality and lineage)
What is a smudge cell count used for?
Is it specific?
Determine CLL
No, also occurs with mono, but it is classically tested
What markers are indivative for B-ALL?
CD10+/CD19+ (B-cell specific)/CD34+ (Blast specific))
CD3- (T-cell)/CD20- (Mature B-cell)
Where can B-ALL expand to?
CSF
Lymph nodes
Bone marrow
Splenic sinusoids
Is hypocellularity a finding with ALL?
Not in bone marrow (hypercellulairty in bone marrow)
Cytopenias would appear in peripheral blood
What are good prognostic genetics for B-ALL?
What are bad prognostic genetics?
Where are the karyotypes taken from?
Good: Hyperdiploidy, t(12;21)
Bad: Hypodiploidy, t(9;22),11q23 abnormalities (MLL)
They are taken from the specific aberrant cells, can be compared to a buccal swab which should find normal karyotypes
What is a large mediastinal mass from an adolescent male indicates?
What would be a charactersitic immunophenotypic finding of this tumor?
T-ALL
CD3+ phenotype
Ratio of B-ALL vs T-ALL
85% to 15%
Definition of acute leukemia
Can it involve extramedullary sites?
What are the two big categories and the morphology/immunophenotype?
>20% blasts in the blood or bone marrow
Yes
Myeloid - CD13,14,15,33,117 w/w/o Auer rods
Lymphoid - CD3,CD19,CD20
What is the pre-leukemic state of AML?
What are the classification states of AML?
Myelodysplasia - Pre-leukemia
AML w/recurrent cytogenic abnormalities
AML w/myelodysplasia-associated changes
AML/MDS, therapy-related
AML, NOS
Prognostic factors in B-ALL
Age (2-10 is good, otherwise bad)
Cytogenetic
Elevated WBC count is poor (>100K/uL)
CSF involvement is poor
Marrow involvement at day 15 is poor
Treatment of ALL (stages)
Induction - Initiate remission
Intensification - Keep up remission
CNS Prophylaxis - Chemo doesn’t enter the brain
Maintenance
How is CNS prophylaxis done for ALL?
What other part of the body needs special concern for ALL?
Irradiation or IT methotrexate
Testes also is protected from chemo
Cure rate for Adult vs Pediatric ALL
Causes of differences?
Adult - 50%
Pediatric - 80-90%
Differences in disease and resillience of the body to handle the chemo
What is so special about bispecific T-cell engaging (BiTE) antibody?
Directs cytotoxic T-cells to CD19 expressing B-cells to kill them
Blinatumonab
How is prognosis for Philidelphia ALL?
What drug improves it?
Horribly bad (7%) Dasatinib raises it up to 40%+
What is the characteristic cell description for CLL?
What are the immunophenotype of CLL?
“Soccer ball” or “Ginger-snap”
CD5+/CD19+/CD20+/CD23+ with monoclonality (single light chain)



